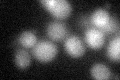

View description
Component of the evolutionarily conserved kinetochore-associated Ndc80 complex (Ndc80p-Nuf2p-Spc24p-Spc25p); involved in chromosome segregation, spindle checkpoint activity and kinetochore clustering
Localization:
Intensity:
Fold change:
Significance:
-
C’ GFP library in SD

below threshold17.62 -
N' NOP1pr-GFP in SD

punctate61.9805 -
N' TEF2pr-mCherry in SD

punctate,nucleus79.7027 -
N' NATIVEpr-GFP in SD

punctate32.139 -
N' TEF2pr-VC and Cyto-VN in SD

#N/A0 -
C’ GFP library in SD+DTT
cytosol22.051.25No -
C’ GFP library in SD+H2O2

cytosol13.790.78No -
C’ GFP library in Starvation Media

cytosol15.80.89No -
C’ GFP library on the background of Pup2-DaMP

below threshold -
C’ GFP library on the background of CCT mutant

below threshold17.86961.01347No
